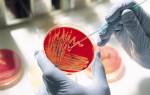

Безусловно, далеко не все скрупулезно анализируют свои экскременты. Да и конструкция нынешних унитазов не располагает к таким исследованиям. Однако появление в каловых массах нехарактерных примесей и включений может быть первым «сигналом тревоги», свидетельствующим о возникновении в организме серьезных проблем. Некоторые из них являются весовым поводом для похода в клинику и обследования.
Обычно наш кал представляет собой достаточно однородную массу. Появление в ней примесей или инородных включений может быть обусловлено как характером рациона, так и развитием заболеваний. Любому здравомыслящему человеку следует насторожиться при появлении в фекальных массах видимых:
- крови;
- гноя;
- слизи;
- пищевых остатков;
- инородных включений.
Кровь
Обнаружение крови в экскрементах всегда является серьезным симптомом, требующим безотлагательного обращения к доктору. Она может быть проявлением (зачастую первым):
- рака кишки;
- воспалительных аутоиммунных болезней кишечника (язвенного колита, болезни Крона);
- крупных доброкачественных новообразований (например, полипов);
- патологии прямой кишки и заднего прохода (трещины, язвы, геморрой, проктиты и др.)
- ишемического колита (обусловленного патологией сосудов, питающих кишечник);
- кишечной ангиодисплазией;
- патологией свертывания крови;
- инфекционным поражением кишки (например, дизентерии, амебиаза, кишечного туберкулеза и др.);
- лекарственным поражением кишки (из-за приема жаропонижающих, нестероидных противовоспалительных средств и др.);
- глистными заболеваниями (аскаридозом, трихоцефалезом и др.).
Количество крови может быть разным: от еле заметных прожилок до нескольких стаканов. Иногда вместо стула при опорожнении кишечника у больного выходит только кровь или кровь со слизью. Цвет крови отражает местонахождение источника кровопотери. Алая свежая кровь характерна для «низкого» расположения (анус, прямая кишка, сигмовидная кишка или нисходящая кишка). Нередко она находится поверх кала. Темная кровь (в особенности, если она смешана с фекальными массами) или кровяные сгустки свидетельствуют о «высокой» локализации, то есть патологический процесс находится в правой части ободочной кишки или в тонкой кишке.
Примесь зеленоватого или желтоватого гноя в экскрементах всегда является признаком серьезного воспалительного процесса. Она появляется при:
- инфекционных колитах;
- проктитах;
- аутоиммунных воспалительных процессах в толстой кишке (язвенный колит, колит Крона);
- дивертикулитах;
- прорыве гнойников в кишку;
- распаде злокачественной опухоли (такое случается на далеко зашедших стадиях болезни).
Поэтому гной в кале тоже считается тревожным сигналом. Самолечение при этих болезнях малоэффективно и может обернуться грозными последствиями.
Слизь
В здоровом кишечнике всегда имеются клетки, вырабатывающие слизь. Она необходима для своевременного прохождения кала по кишке. Поэтому малое количество прозрачной слизи в фекалиях может встречаться и в норме. Кроме того, небольшие вкрапления или комочки слизи характерны для стула младенцев, питающихся грудным молоком. Они связаны с излишней жирностью материнского молока, с которой не в состоянии справиться еще слабые пищеварительные ферменты детского организма. Однако большое количество слизи, желтоватая или коричневатая ее окраска нередко являются проявлениями:
- повышенной двигательной активности кишечника;
- инфекционных заболеваний (сальмонеллез, брюшной тиф, дизентерия и др.);
- воспалительных процессов в кишечнике неинфекционного происхождения (дивертикулит и др.);
- глистных заболеваний;
- новообразований;
- муковисцидоза.
Кроме этого, слизь бывает спутником запоров и предвестником обострения хронических аутоиммунных болезней кишечника (болезни Крона или язвенного колита).
Остатки пищи
Некоторые виды пищи невозможно полностью переварить, поэтому присутствие семечек, маковых зернышек, косточек, фрагментов плотной кожуры, жилок и хрящей мяса, костей рыбы не должно быть причиной для беспокойства. Пищеварительные ферменты не способны справиться с такой грубой клетчаткой и соединительной тканью.
Насторожиться следует, если в стуле заметны остатки мяса, яиц, творога, жира. Их присутствие отражает тяжелую недостаточность образования нужных для пищеварения ферментов. Такое бывает при:
- распространенной и тяжелой атрофии желудочной слизистой;
- угнетении выработки панкреатического сока (следствие панкреатитов или удаления части поджелудочной железы);
- недостаточности кишечных ферментов.
Также остатки пищи в фекалиях наблюдаются при ускоренной моторике кишки (синдроме раздраженного кишечника).
Инородные включения
Иногда при рассматривании каловых масс в них можно увидеть округлые или продолговатые белые или светло-желтые плотные включения. Это могут быть фрагменты глистов (цепней) или сами черви (острицы, власоглав, аскариды и др.). Крайне желательно собрать такой кал со всеми инородными телами и отнести в лабораторию клиники инфекционного профиля. Ведь лечение глистных заболеваний во многом зависит не только от самого факта наличия, но и от вида обнаруживаемых червей.
Пленки в стуле могут появляться при серьезном поражении кишки: псевдомембранозном колите, связанным с лечением антибиотиками. Иногда же мнительные пациенты за пленки или глистов принимают плотные комочки слизи. Кроме того, в ряде случаев в экскрементах могут содержаться остатки оболочек лекарств (чаще гранулированных) или самих препаратов (например, крупинок активированного угля).
Таким образом, появление в фекальных массах тех или иных примесей должно настораживать пациентов. Большинство из этих включений требует комплексного обследования и активных врачебных действий.
К какому врачу обратиться
Если у вас появились примеси в кале, обратитесь к гастроэнтерологу. Если такой возможности нет, первичную диагностику осуществят терапевт или семейный врач. После уточнения диагноза пациенту может быть назначен осмотр проктолога, онколога, хирурга, гематолога, инфекциониста. Для диагностики очень важна квалификация врача-эндоскописта и применяемое им оборудование.
Видео версия статьи:
Смотрите видео по теме: анализ кала у ребенка, правила сбора и хранения биоматериала.
Клостридиями называют микроорганизмы, которые относятся к грамположительным спороносным бактериям. Название «Клостридии» происходит от греческого слова «κλοςτεδ», которое переводится как «веретено». Бактерии получили его благодаря свойству раздуваться при спорообразовании, что внешне напоминает круг веретена. Они обитают в кишечнике и являются неотъемлемой частью микрофлоры, необходимой для нормального функционирования организма.
Их главное предназначение – расщеплять белок для преобразования его в аминокислоты. Эти анаэробные микроорганизмы размножаются через продукцию эндоспор и способны получать ресурсы для жизнедеятельности в любых условиях, даже при низком уровне кислорода, что делает их устойчивыми к разного рода изменениям среды.
Количество клостридий непостоянно и растет в зависимости от возраста человека. Например, у маленьких детей их количество может достигать десяти тысяч колониеобразующих единиц, и это считается нормой. Клостридии в кале у взрослого человека не старше 60-ти лет можно обнаружить в количестве порядка 105 КОЕ/г, а у людей старше 60-ти лет – до 106 КОЕ/г. Но чрезмерное увеличение количества этих бактерий может навредить человеческому организму, а в редких случаях – привести к летальному исходу.
При скоплении большого количества клостридий выработка продуктов их жизнедеятельности может привести к образованию токсинов, которое негативно сказываются на кровеносной, нервной системе, а также может вызвать некроз тканей.
В медицинской практике различают такие виды вредоносных клостридий:
- Clostridium botulinum вызывает ботулизм.
- Clostridium tetani становятся причиной столбняка, поражая при этом нервную систему, могут вызывать судороги.
- Clostridium perfringens вызывают интоксикацию, диарею, тошноту, колики, лихорадку и газовую гангрену.
- Clostridium difficile входят в состав нормальной микрофлоры, обитают в основном в толстой кишке.
Однако стремительное увеличение их количества в сочетании с действием некоторых антибиотиков может провоцировать диарею, колики. Лечением Clostridium difficile в случае, когда их количество превышает допустимую норму, должен заниматься только врач. К тому же большое скопление этих микроорганизмов может стать причиной различных заболеваний мочеполовой системы и простатита.
https://youtube.com/watch?v=c55qvAWEGww
Причины
Разнообразие клостридий в анализе здорового человека может достигать сотен видов, большинство из которых не являются опасными, но все же чрезмерное увеличение количества этих микроорганизмов может серьезно ухудшить общее состояние больного. Главной причиной инфицирования патогенными микроорганизмами является нарушение правил личной гигиены.
Клостридии при выводе каловых масс попадают в почву и воду в виде спор и могут существовать там длительное время. Существует ряд факторов, которые могут спровоцировать опасное их скопление в организме человека:
- плохая экология.
- стрессы и частое нервное напряжение.
- плохой иммунитет.
- гипоксия мозга.
- простудные заболевания.
- нерегулярный сон и частая утомляемость.
- употребление вредных продуктов питания.
- различные хирургические вмешательства.
- другие инфекции кишечника.
Симптомы
Основные симптомы, которые наблюдаются чаще всего у детей и людей среднего возраста – это жидкий стул, вздутие живота и колит. На этой стадии лечить клостридии необходимо с помощью антибиотиков. Выделяют еще ряд симптомов, которые сопровождаются ростом спор C.difficile:
- регулярная температура выше 39°;
- снижение аппетита;
- потеря веса;
- боли в животе;
- чувствительность кишечника при ощупывании;
- частая рвота;
- наличие крови, слизи в каловых массах.
Диагностика
Обнаружив подобные симптомы, необходимо как можно быстрее обратиться к инфекционисту или гастроэнтерологу, чтоб провести исследования на предмет наличия в организме патогенных микроорганизмов, назначить лечение клостридии в случае подтверждения диагноза. Лабораторные исследования будут направлены на подтверждение чрезмерного скопления спор C.difficile в фекалиях пациента, а также наличие энтеротоксинов (А) и цитотоксинов (В), которые представляют собой продукты жизнедеятельности клостридий.
Токсины А и В являются причиной заболеваний, которые могут серьезно навредить клеткам эпителия кишечника и вызвать его расстройство.
Существует важный фактор для успешной диагностики – анализы необходимо сдать сразу же после появления первых симптомов, так как в этом случае врач сможет со 100% вероятностью определить, было ли расстройство кишечника больного вызвано обычным дисбактериозом либо продуктами жизнедеятельности микроорганизмов, если клостридии в анализе обнаружены в большом количестве.
Если у пациента нет возможности своевременно отнести анализы в лабораторию, собрав материал в специальную емкость, которая продается в аптеках, его можно хранить в течение 3-х дней при низкой температуре (2-80C). Это не повлияет на результаты. Но для более длительного хранения температуру стоит понизить до 20 градусов ниже ноля.
Для выявления токсинов А и В в фекалиях лаборанты используют иммуноанализ, так как этот вид исследований поможет определить их концентрацию в организме. И только по результатам анализов врач сможет назначить правильное лечение, чем быстрее больной обратится за помощью, тем щадящими будут препараты.
Лечение
При повышении общего числа клостридий лечение у взрослых врач может назначить Креон, Энтерол, Бактериофаг. Действие этих препаратов направлено на заселение микрофлоры кишечника полезными бактериями, которые смогут снизить концентрацию клостридий и нормализовать их жизнедеятельность.
Если же у больного обнаружилась симптоматика клостридиоза, то назначается терапия, которая направлена на нейтрализацию выработки токсинов и способствует реабилитации микрофлоры кишечника. Первым шагом успешного лечения будет прекращение приема антибактериальных средств, так как они провоцируют рост спорообразования этих микроорганизмов.
Успешно нормализовать микрофлору кишечника способствует лечение Бактериофагом, но также для этой цели подойдут Линекс, Хилак-Форте, Лактобактерин и т. д. Но стоит помнить, что самостоятельная терапия может только усугубить ситуацию.
Без получения определенных результатов анализов ни один больной и ни один врач не способен поставить корректный диагноз и назначить эффективное лечение.
Если заболевание обнаружено у детей, то им в срочном порядке назначают лечение Бактериофагом, специально разработанную диету, вводят определенные ограничения относительно времяпрепровождения:
- ограничение мясных изделий.
- соблюдение тщательной гигиены.
- сокращение времени общения с животными.
- ограниченный контакт с землей.
Профилактика
Помимо применения препаратов, способствующих нормализации микрофлоры кишечника, можно обозначить ряд мер, которые в дальнейшем могут обезопасить вас от образования чрезмерного количества клостридий. Особенно эти профилактические меры актуальны для детей.
- Строгое соблюдение гигиены.
- Использование только свежего мяса при приготовлении пищи, исключая заморозку и длительное хранение.
- Достаточная термическая обработка продуктов, которые этого требуют (мясо, рыба).
- Тщательное мытье овощей и фруктов.
- Обязательное мытье рук с мылом после посещения туалета, общественных мест.
- Применение дезсредств в домохозяйстве.
- Соблюдение всех предписанных гигиенических норм при кормлении новорожденных.
- Если в доме есть животные, то им необходим регулярный ветеринарный осмотр.
Придерживаясь этих простых правил, можно обезопасить себя от многих проблем со здоровьем.
Важно также помнить, что своевременное обращение к специалисту – обязательное условие для успешного лечения.
Самолечение в лучшем случае ничего не изменит, в худшем – усугубит ситуацию. Поэтому, обнаружив у себя тревожные симптомы, следует незамедлительно обратиться к специалисту.
Когда при анализе обнаруживаются цисты простейших в кале, это могут быть симптомы бластоцистоза. Неприятное заболевание, характеризующееся проявлением кишечного дискомфорта, успешно лечится, но гораздо лучше предотвратить его появление и заняться профилактикой.
Что такое бластоцисты
Толстый кишечник даже здорового человека и детей – место обитания простейших. Там живут бластоцисты хоминис. Они стали известны около 50 лет назад и подверглись изучениям. Вначале их считали непатогенными микроорганизмами, но вскоре выяснилось, что они могут распространяться, размножаться и совершать перенос заболеваний протозойного инфекционного типа. Ученые говорят, что бластоцисты участвуют при развитии кишечной патологии, вызывая болезнь бластоцистоз.
Классификация бластоцист
По внешнему виду выделяют следующие бластоцисты, которые при неблагоприятных условиях образуют цисты – клетки с утолщенной стенкой:
- Вакуолярная бластоциста – имеет вид вакуоли. Снаружи имеет размер до 20 мкм, внутри есть до 4 ядер, митохондрии и большая вакуоль, куда можно деть питательные вещества.
- Гранулярная бластоциста – похожа на вакуолярную, но тут содержимое вакуоли и цитоплазмы внешне похоже на гранулированную субстанцию. Внутри есть липиды, гликоген, миелиноподобные структуры.
- Микроскопическая авакуолярная, амебная форма – имеют тип эмбриона, место обитания – толстый кишечник, имеют малый размер до 5 мкм. Подвержены быстрому разрушению за пределами толстой кишки. Амебная форма неподвижна, живет вблизи стенок кишечника.
- Мультивакуолярная бластоциста – представляет собой группу авакуолярных форм, место обитания – полость кишечника. Внутри есть цитоплазма с несколькими вакуолями. Им характерна плотная внешняя оболочка, нужная для защиты от неблагоприятных действий.
Симптомы бластоцисты у взрослого
Когда врачи обнаруживают бластоцисты в кале у взрослого, то это свидетельствует о заболевании. До клинического исследования понять о наличии патогенной инфекции можно по следующим симптомам у взрослого, которые проявляются только при снижении иммунитета:
- спазм, боли в животе;
- кал жидкой консистенции;
- резкое похудение;
- отказ от пищи;
- частота рвоты;
- лихорадка;
- зуд на коже.
Заразиться бластоцистами может ребенок и взрослый в случае употребления грязной воды, плохо промытых фруктов и овощей, через грязные руки и простые предметы. Микроорганизм попадает через желудок в толстый кишечник ребенка, где и начинает свою активную жизнедеятельность. Там же простейшее размножается, погибает, выделяет продукты интоксикации, отравляя организм.